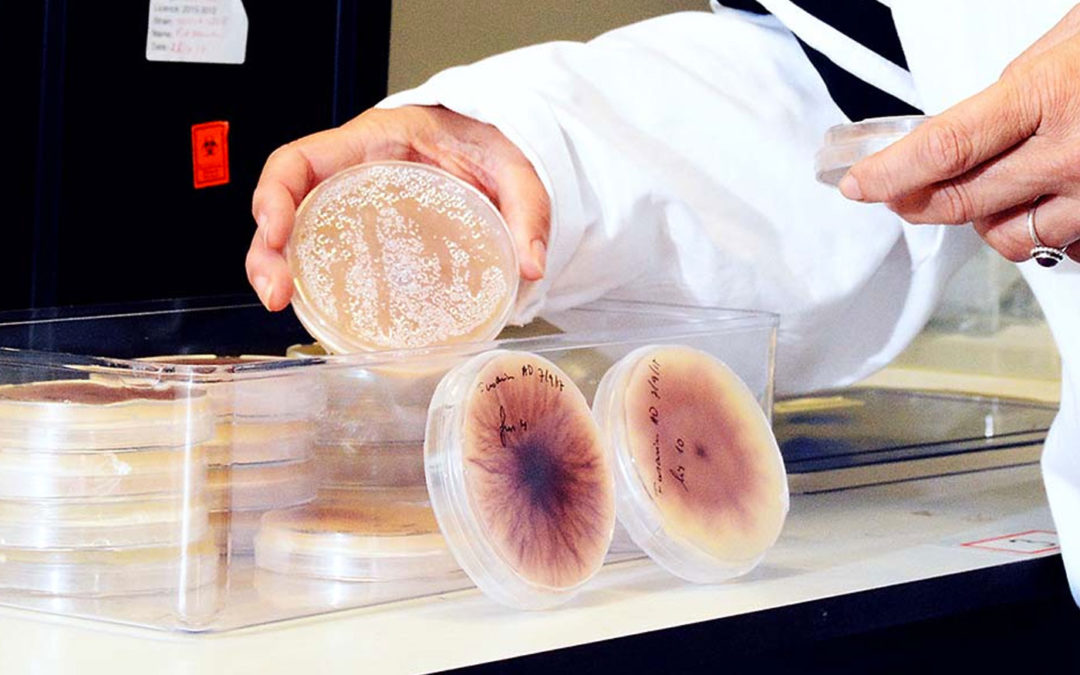
Onderzoek naar betere identificatie, meer zicht op verspreiding en biologische bestrijding

Het ministerie van EZ heeft financiering toegekend aan onderzoek om meer grip te krijgen op Fusarium. De schimmel vormt een toenemend probleem in een groot aantal teelten en is moeilijk aan te pakken. Het onderzoek moet zorgen voor een betere identificatie-methode, meer zicht op de verspreiding en biologische bestrijdingsmethoden.
Tuinbouwbreed heersen zorgen over Fusarium. De schimmel is extreem variabel, weet resistenties snel te overwinnen en is resistent tegen veel fungiciden. Om de problemen te lijf te kunnen gaan, moet het inzicht op veel vlakken groeien. Daartoe is vorig jaar het Masterplan Fusarium opgesteld. Toen lukte het niet om de financiering rond te krijgen.
Nu heeft het ministerie van EZ toegezegd driekwart van het budget, goed voor drie onderdelen van het masterplan, alsnog toe te kennen, met cofinanciering van LTO Glaskracht Nederland en het bedrijfsleven. De afrondende gesprekken daarover zijn gaande.
Fusarium erg variabel
“Het gaat om de onderdelen Diagnostiek, Epidemiologie en Biocontrole”, vertelt onderzoekster Anne van Diepeningen van Wageningen Universiteit & Research, onderdeel Biointeracties en Plantgezondheid. Samen met collega Cees van Waalwijk trekt zij het onderzoek. Het wordt uitgevoerd op de locaties in Wageningen en Bleiswijk.
“Binnen het onderdeel Diagnostiek willen we merkers ontwikkelen. Dat zijn kleine stukjes DNA, die karakteristiek zijn voor een ziekteverwekkende variant. Daarmee is in de toekomst snel te achterhalen om welke variant het gaat”, vertelt ze. Omdat Fusarium zo variabel is, en zich specialiseert op een gastheer, is dat een hele zoektocht. Het genetische verschil tussen een ziekteverwekkende en een onschuldige soort is namelijk vaak zeer gering.
Zicht op besmettingsroutes
“Het tweede onderdeel is Epidemiologie. Daarbij willen we veel meer zicht krijgen op waar de schimmel zich verstopt. Bij grondteelt bijvoorbeeld duikt hij na het stomen van de grond na verloop van tijd vaak weer op. Het is dan de vraag of hij bijvoorbeeld in water overleeft”, vertelt ze.
Het derde onderdeel is biologische bestrijding, een belangrijk punt omdat chemische aanpak vaak moeilijk is: de schimmel is onvatbaar voor veel soorten fungiciden. “Je kunt denken aan de inzet van onschadelijke fusariumsoorten, die voorkomen dat een schadelijke variant zich kan vestigen. Ook sommige soorten bacteriën en schimmels bieden wellicht mogelijkheden”, zegt ze. Het nieuws over de financiering van dit onderzoek is in de sector met gejuich ontvangen.
In de komende november editie van Onder Glas staat een onderzoeksartikel over Fusarium.
Tekst: Tijs Kierkels